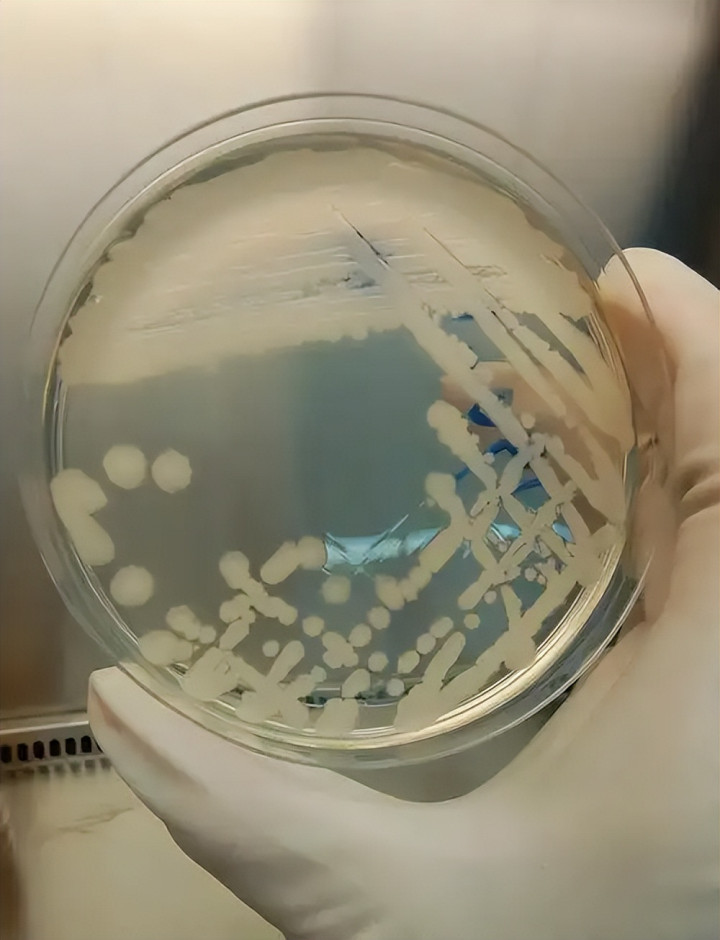

奶粉是无数家庭喂养宝宝的核心选择,家长们往往愿意花高价认准知名品牌,只为换一份安心。
可近日全球食品巨头雀巢的一则召回公告,让不少家长揪紧了心。
这家知名企业宣布在欧洲多国召回数批次婴儿奶粉,原因是产品原料中可能存在致病菌隐患,这类隐患会直接威胁孩子的健康。

而且此次召回并非突发,而是此前单国召回的延续,更让人担忧的是,目前仍有很多家庭在不知情的情况下使用涉事奶粉。
这些含隐患的奶粉究竟会给孩子带来哪些伤害?家长们又该如何快速排查自家手中的产品是否安全?

其实最早在2025年底,他们就因为原材料不太对劲,在法国下架过一批婴儿奶粉。
可谁知道,刚过完年,2026年1月,这事儿就越闹越广——德国、奥地利、丹麦、意大利等六个欧洲国家都跟着召回,后来更是蔓延到全球31个地方。
这架势说明,起初以为只是某个批次出差错,实际上问题严重得多。

雀巢后来承认,这次奶粉召回主要是因为其中添加的一种原料——花生四烯酸油脂出了问题。
供应商提供的这批料,可能被一种叫“蜡样芽孢杆菌”的坏东西污染了。
这名字听着可能有点陌生,但危害不小,尤其对婴幼儿。
英国那边的食品监管部门早就提醒过,这种细菌很“扛煮”,普通冲奶粉的热水根本烫不死它。
宝宝要是吃进去了,很可能又拉又吐,肚子还疼。
小不点儿们本来体质就弱,一脱水就更麻烦。
万一细菌窜进血液里,还可能引起更严重的全身感染,损伤肝脏肾脏。
对于早产或者体重偏轻的宝宝来说,情况可能更危险,可不能掉以轻心。

可雀巢说这是“预防性召回”,目前还没出现孩子生病的确定病例——这话听了,当爹妈的哪能放得心?
小宝宝身体那么嫩,免疫系统都没长全,哪怕风险再小,也没人敢拿自己孩子去赌。
再说了,雀巢这家全球数一数二的食品公司,可不是头一回出岔子。
之前就多次因为营养含量不达标、卖货渠道不合规这些事,被好几个国家的监管部门点名,奶粉也召回过不止一次。
巨头品牌在品控上一次次掉链子,实在让家长们心里发凉。

现在最麻烦的是,不少家长可能还在不知不觉中给孩子喂着有问题的奶粉。
毕竟这些奶粉在海外名字五花八门,像欧洲常见的Guigoz、Nidal系列,咱们通过代购或海淘买回来时,根本不知道它们和出事的产品是同一款。
雀巢目前只在自己各国当地的网站上贴了召回通知和批次号,可那些通过跨境渠道买奶粉的家长,完全收不到直接提醒。

同时,不少代购和电商平台也没主动去核对货架上的奶粉是否在召回名单里,更别提通知已经购买的顾客了。
这就导致一批本该下架的产品,还在市场上悄悄流通,很多家庭完全蒙在鼓里。

事情在1月7日有了进展,雀巢中国终于出面说明,确认中国大陆有少量产品可能涉及这次问题,已经开始自愿回收。
具体包括力多精、铂初能恩等品牌的约30个批次。
他们也特别提到,家长常买的超启能恩、启赋等系列不在影响范围内,金沙电玩app大家不必过度紧张。

但眼下最实际的困难是,很多家庭根本搞不清自己手里的奶粉是不是问题批次。
尤其是那些通过代购等非官方渠道买来的,连外包装信息都未必看得全,想问清楚该找谁都不知道,实在让人心里没底。

其实对于奶粉里可能存在的有害细菌,监管部门早有警觉。
去年三月,国家市场监管总局就出台过一份安全指引,里面特别点名了像蜡样芽孢杆菌、克罗诺杆菌这类危险菌种。
文件里写得明明白白:给半岁以内小宝宝吃的配方奶粉,是绝对不允许检出克罗诺杆菌的。
可既然早有规定,为什么还是防不住呢?
说到底,问题还是出在具体的生产把关和日常监督环节——规定有了,但执行过程中显然存在漏洞。

雀巢这样的大企业,在原料把控上确实存在疏漏。
他们过于相信供应商自己的质检报告,而没有对每批进货的原料都委托独立机构进行全方位检测,这就给问题原料混入生产线留下了缺口。
另一方面,跨境流通的监管衔接也不顺畅。
虽然欧盟设有食品安全警报机制,但相关信息传到国内往往滞后,导致通过海淘、代购等渠道购买奶粉的中国家庭,很难第一时间了解到产品在海外是否已被召回。
这种信息差,让风险产品有了继续流通的空间。

无论你家喝的是不是雀巢,只要是进口奶粉,最近都最好抽空核对一下产品信息。
如果发现奶粉正在召回名单里,不管罐子开没开,都千万别再给宝宝喝了,别心疼那点钱。
要是孩子已经喝过一些,接下来两天多留意有没有腹泻、呕吐或者发烧,看看精神头怎么样。
只要觉得不对劲,马上带他就医,记得把奶粉罐也一起拿给医生看。

同时,购买时的收据、订单记录、付款截图这些都保存好。
根据咱们国家的《食品安全法》,如果买到了不安全的食品,不仅可以退货,还能要求十倍货款或者三倍损失的赔偿,这是正当权利,该争取就要争取。
万一商家推脱不处理,可以直接拨打市民服务热线,或者通过微信小程序“全国12315平台”提交投诉。
{jz:field.toptypename/}市场监督管理部门收到后,一般会在7个工作日内联系你并跟进处理。

最后想提醒家长们,别盲目迷信“洋奶粉”。
很多人觉得进口的就更安全,其实进口奶粉也可能出问题,之前就有荷兰、新西兰的进口奶粉因为检出致病菌被销毁。
不管是国产还是进口,只要符合中国2025年实施的新国标,通过正规渠道购买,能查到完整的追溯信息,才是靠谱的选择。
现在国家对奶粉行业的监管越来越严,新国标实施后,不少不合规的品牌会被淘汰,正规品牌的质量也会更有保障。

孩子的口粮安全是天大的事,希望这些信息能帮助更多爸妈及时检查家里的奶粉。
这件事也提醒我们,生产企业必须真正负起责任,把好质量每一关;监管部门也要加强监督,堵住漏洞。
只有各方都做到位,家长们才不用整天为“宝宝这一口”是否安全而担忧。
